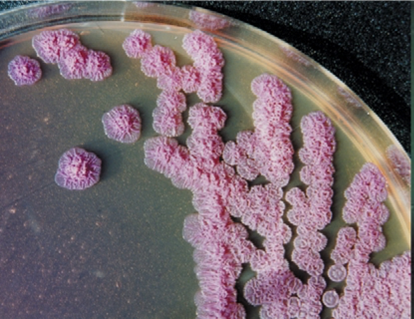

实验猴的国际贸易中,常常会在运输和检疫过程中遇到各种传染病问题,其中类鼻疽就是近年来倍受国际进口商和疾控部门关注的一种传染病。类鼻疽是一种由革兰氏阴性杆菌类鼻疽伯克霍尔德菌(Pseudomonas pseudomallei)感染引起的疾病。这种疾病可以感染人类、非人灵长类动物、其他哺乳动物、鸟类和爬行动物等。人类鼻疽临床表现多样,极易漏诊,从而延误治疗时机,通常感染后死亡率为10-50%,但如果发展为脓毒症死亡率则可高达90%。东南亚地区、澳大利亚北部、我国海南、广西、广东等为疫源地,其中,东南亚地区发病率最高。
病原学
类鼻疽伯克霍尔德菌属于假单胞菌科,伯克霍尔德菌属,菌体呈短杆状,两端浓染,其对营养要求不高,在营养缺乏的蒸馏水中也可存活数年,而且对大多数抗菌药有耐药性。常用消毒剂(如75%的乙醇、0.5%的碘伏、0.3%的氯己定和2%的84消毒液)能在3~10 min内迅速杀灭此菌。该菌在绵羊血琼脂、麦康凯琼脂、Ashdown琼脂等多种培养基上均可生长。于1912年被首次分离到,并于1921年将该菌所致疾病命名为类鼻疽(Melioidosis)。根据《人间传染的病原微生物名录》(2023版)该菌的危害程度分类和结核分枝杆菌、布鲁氏菌等一样同属于第二类,需要在BSL-2实验室进行样本检测,如果涉及活菌操作则要在BSL-3实验室进行。该菌现在也被美国CDC列为生物攻击潜在病原体(B类),是潜在的生化武器制剂。
流 行 病 学
该细菌常存在于热带地区的土壤和泥水中,常常在暴雨、洪水等天气过后,通过摄入、吸入、开放伤口、皮肤擦伤而感染人或动物。而其在动物与动物、动物与人及人与人之间相互传播十分罕见。人感染后的潜伏期差异很大,从一天到几年不等,但大多数情况下症状会在暴露后的1-21天内出现。动物的潜伏期则不明确,但考虑到灵长类动物与人类的亲缘关系很近,可以推断非人灵长类动物的潜伏期与人类的潜伏期类似。
随着全球气候变化发生、交通便利,以及经济、贸易、文化交流的频繁,类鼻疽的人群感染率有逐年增长趋势。2015年,全球约有16.5万例相关病例,其中8.9万人死亡。已有越来越多原来不是疫源地的国家和地区出现本土病例,人群中出现更多感染病例的风险正在扩大。而原产于东南亚的非人灵长类动物在其本土及我国海南、广西、广东等地也都面临着同样的风险。
临 床 症 状
类鼻疽最大的特点是形成脓肿,特别常见于肺、肝、脾、骨骼肌和前列腺等。在东南亚三分之一的儿童感染病例都表现为腮腺脓肿。在澳大利亚北部,4%的患者表现为脑干脑炎。而在我国,血流感染是最常见的感染类型,例如在我国主要疫源地海南,2012-2021年,从患者的各类标本中分离到825株类鼻疽伯克霍尔德菌,其中71.4%分离自血液样本,且发病数量呈逐年递增趋势。

图2 患类鼻疽的食蟹猴肝脏、脾脏、肺、脊柱的病变
2021年1月,美国从柬埔寨进口的一批食蟹猴在检疫期对动物进行常规体检时发现一只动物的腰骶部有一个1 cm ×1 cm的皮下肿块,在随后的实验室检测中确认其为类鼻疽伯克霍尔德菌感染所致的类鼻疽病。这之后又从其它来自柬埔寨的进口动物中发现了5例病例,其中有4例是在完成隔离检疫后才发病并被确诊的。
治 疗
类鼻疽伯克霍尔德菌对常见抗菌素具有天然耐药性,包括第一代内酰胺类、氨基糖苷类、大环内酯类和氟喹诺酮类药物。
人的类鼻疽治疗包括两个阶段:
1.强化治疗阶段,头孢他啶或碳青霉烯类静脉给药至少10-14天;
2.根除治疗阶段,口服抗生素治疗(甲氧苄啶/磺胺甲恶唑或强力霉素) 3-6个月。
如果在停止治疗时感染未完全清除,可能会复发。使用了不适当的抗生素或疗程过短,类鼻疽复发的可能性较大。即使是经过规范的强化和根除治疗后,人类鼻疽患者依然有5% -28%的复发率。在动物中,出于担心人畜共患病传播、治疗时间过长、还有复发的可能性及存在将该病原引入非流行地区的可能性等因素的考量,通常会将检测阳性动物安乐死。
检 测
在进行诊断检测时,最常用的方法是细菌分离培养和PCR检测。需要注意的是,在使用生化鉴定时,现在市面上常用的商业鉴定数据库可能会将类鼻疽伯克霍尔德菌与洋葱伯克霍尔德菌(B. cepacia)、泰国伯克霍尔德菌(B. thailandensis)等混淆。而在使用分子生物学方法时,如果直接用血液、环境样本、组织进行PCR检测可能因菌量太小而发生漏检。挑取纯培养物进行PCR扩增可以解决这一问题。另外,如果用16sRNA测序,由于基因序列差异小,依然会和泰国伯克霍尔德菌发生混淆,而groEL基因有更好的鉴别效果。进行鉴定检测的实验室必须充分了解类鼻疽伯克霍尔德菌可能存在的漏检、混淆的情况,在出现疑似病例时,应慎重对待,在做好生物安全防护的前提下使用可靠的鉴定方法。
结 语
虽然目前实验猴的类鼻疽伯克霍尔德菌感染比较少见,但对于那些来自疫源地的动物,应该防范该致病菌感染所导致的高死亡率以及其所带来的生物安全风险。实验猴养殖单位、进口商、检疫部门和使用单位应该对该病提高警惕,严格检疫,定期监测,一旦遇到疑似案例应及时鉴定并果断处理,切断传染途径,减小扩散风险。



